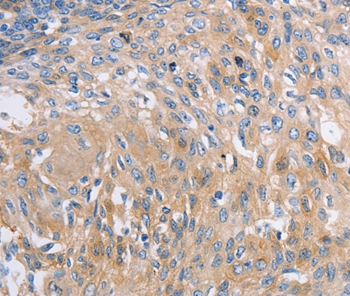

Immunohistochemistry analysis in human cerebral cortex and liver tissues using HPA040385 antibody. Corresponding NBEA RNA-seq data are presented for the same tissues.
Anti-NBEA Antibody
HPA040385
ApplicationsImmunoCytoChemistry, ImmunoHistoChemistry
Product group Antibodies
ReactivityHuman
TargetNBEA
Overview
- SupplierAtlas Antibodies
- Product NameAnti-NBEA Antibody
- Delivery Days Customer4
- ApplicationsImmunoCytoChemistry, ImmunoHistoChemistry
- CertificationResearch Use Only
- ClonalityPolyclonal
- ConjugateUnconjugated
- Gene ID26960
- Target nameNBEA
- Target descriptionneurobeachin
- Target synonymsBCL8B, LYST2, NEDEGE, neurobeachin, lysosomal-trafficking regulator 2
- HostRabbit
- IsotypeIgG
- Protein IDQ8NFP9
- Protein NameNeurobeachin
- Scientific DescriptionRecombinant Protein Epitope Signature Tag (PrEST) antigen sequence
- ReactivityHuman
- Storage Instruction-20°C,2°C to 8°C
- UNSPSC41116161